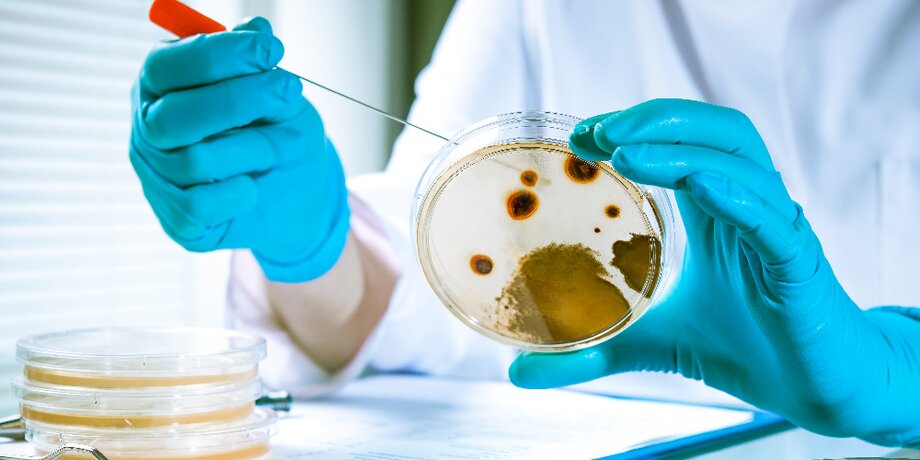

В России существуют риски распространения холеры, но они сведены к минимуму. Об этом заявила глава Роспотребнадзора Анна Попова. Она подчеркнула, что в стране принимаются все необходимые меры для защиты населения. Ранее во Всемирной организации здравоохранения (ВОЗ) сообщили, что сегодня в 22 странах борются со вспышками холеры. Рассказываем подробности, а также разбираемся, из-за чего она распространяется.
Россиянам нечего бояться?
Глава Роспотребнадзора Анна Попова заявила, что в последний год в странах, в которых наблюдались засуха и гуманитарные потрясения, были проблемы, связанные с холерой. "Мы эти риски видим и оказываем помощь", – отметила она.
Вместе с тем, по словам Поповой, в России принимаются все меры по защите населения от инфекции. В 2023 году ни одного случая заболевания в стране не выявлено, сказала она.
"Хочу также отметить, что наше население достаточно грамотное, люди соблюдают гигиену – моют руки и продукты питания. Я считаю, что в нашей стране риски холеры минимальны, но они есть. Поэтому мы делаем все, чтобы их не допустить", – подчеркнула Попова.
Ранее сообщалось, что после землетрясений в Турции и Сирии может обостриться ситуация с холерой. Об этом предупредил врач-эпидемиолог, академик РАН Геннадий Онищенко.
Ответственный подход каждого
Ведущий научный сотрудник Федерального исследовательского центра фундаментальной и трансляционной медицины Александр Чепурнов в беседе с Москвой 24 заявил, что в России для распространения холеры нет предпосылок.
"Больших проблем я не жду... Еще, можно сказать, зима, а эта инфекция любит тепло", – объясняет эксперт.
По словам специалиста, качественные санитарные меры вполне в состоянии справиться с холерой. К тому же для лечения заболевания есть достаточное количество лекарств. Вместе с тем Чепурнов напомнил о наличии прививок от инфекции. "Сейчас хороший спектр вакцин... Обычно прививают, например, врачей. Прививки для населения используют только в экстренных случаях", – добавил он.
Эксперт также согласился, что в зоне риска по распространению холеры сейчас находятся Турция и Сирия, где недавно случились землетрясения, поскольку было много погибших.








Сергей Собянин рассказал о космических проектах, реализуемых в Москве